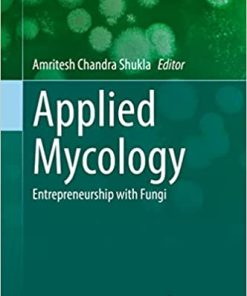
Applied Mycology Entrepreneurship with Fungi

Sale!
Epidemiology Books
ISBN 9781108480574
Original price was: ₨ 1,500.₨ 1,200Current price is: ₨ 1,200.
Sale!
Dentistry Books
ISBN 9781850972778
Original price was: ₨ 100.₨ 20Current price is: ₨ 20.
Sale!
Nephrology Books
ISBN 9783030708962
Original price was: ₨ 2,500.₨ 2,200Current price is: ₨ 2,200.
Sale!
ISBN 9798665241647
Original price was: ₨ 1,000.₨ 700Current price is: ₨ 700.
Sale!
Nephrology Books
Approaches to Chronic Kidney Disease A Guide for Primary Care Providers and Non Nephrologists
ISBN 9783030830816
Original price was: ₨ 2,500.₨ 2,100Current price is: ₨ 2,100.
Sale!
Cardiology Books
Approaches to Left Atrial Appendage Exclusion An Issue of Interventional Cardiology Clinics
ISBN 9780323290029
Original price was: ₨ 1,000.₨ 750Current price is: ₨ 750.